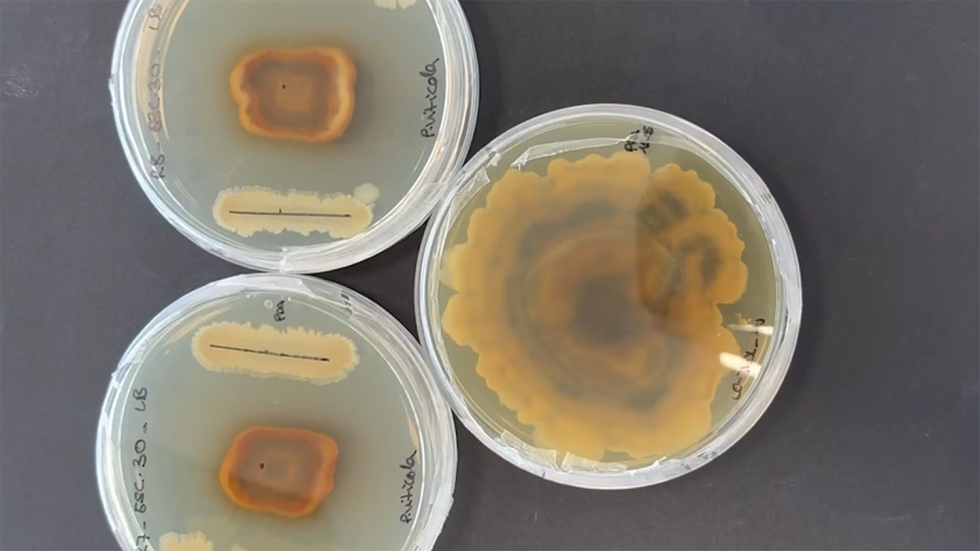
Se han perfeccionado procesos de hidr�lisis qu�mico-enzim�tica con el fin de liberar nutrientes clave a partir de subproductos de la industria...

Proyecto ESCUDO
ITENE desarrolla bioestimulantes y agentes de biocontrol a partir de residuos agrícolas

El centro tecnológico ITENE ha logrado avances clave en el desarrollo de bioestimulantes microbianos y extractos botánicos biocidas elaborados con subproductos agroforestales como la cascarilla del arroz, los sarmientos y orujos de la vid, y las pieles de cítricos con porcentajes de inhibición de hasta el 70%.
Llevado a cabo en el marco del proyecto ESCUDO, financiado por el Instituto Valenciano de Competitividad Empresarial (IVACE+i) a través del Fondo Europeo de Desarrollo Regional (Feder), entre junio de 2024 y 2025, el desarrollo busca reducir la dependencia de los agroquímicos convencionales para mejorar los cultivos y las explotaciones forestales.
El trabajo se ha desarrollado bajo la premisa de fomentar la valorización de los residuos agrícolas y emplear herramientas biotecnológicas para hacer más eficiente el uso de nutrientes, mejorar el crecimiento de los cultivos y aumentar su resistencia frente al estrés biótico y abiótico.
Uso de microorganismos autóctonos beneficiosos
Para alcanzar sus metas, ante el aumento de enfermedades fúngicas como mal de pie, bakanae, tizón del arroz, excoriosis o black rot, el proyecto apuesta por el uso de microorganismos autóctonos beneficiosos. Estos agentes microbianos han sido aislados de los propios cultivos de arroz y vid, y pueden ser cultivados en medios de bajo coste, preparados a partir de subproductos, alcanzando altas tasas de crecimiento. Durante el proceso de validación de la actividad bioestimulante y biocontrol, los nuevos desarrollos han demostrado no presentar fitotoxocidad en los cultivos empleados.
En 2023 el 79% de los fungicidas eran químicos. Por ello es necesaria la fabricación de productos innovadores y respetuosos con el suelo, como son los bioestimulantes y biopesticidas, para lograr una agricultura sostenible que garantice la seguridad alimentaria, promueva ecosistemas saludables y apoye la gestión sostenible de la tierra, el agua y los recursos naturales, explica Cristina Pérez, responsable técnica del proyecto en ITENE.
Para ello, se ha llevado a cabo la selección y aislamiento de cepas microbianas, que posteriormente se analizan por sus propiedades bioestimulantes y antifúngicas frente a patógenos que afectan a los cultivos. Paralelamente, se han perfeccionado procesos de hidrólisis químico-enzimática con el fin de liberar nutrientes clave a partir de subproductos de la industria agroalimentaria como la cascarilla de arroz; sarmiento, raspón y orujos de uva; así como pieles de fruta. Estos compuestos nutritivos se emplean para cultivar de forma eficiente las cepas microbianas en medios específicos.
Asimismo, se verifica que los microorganismos mantengan su capacidad bioestimulante o de biocontrol durante el proceso productivo y de escalado. Las primeras pruebas se realizan en semillas y posteriormente en condiciones controladas en maceta. Las soluciones desarrolladas se aplican mediante pulverización foliar, incorporación al suelo o a través del sistema de riego, con el fin de promover el crecimiento vegetal, mejorar la calidad del producto final y reforzar la resistencia de los cultivos frente al estrés abiótico, tanto en agricultura como en silvicultura.
Los resultados obtenidos no solo ofrecen una alternativa eficaz a los tratamientos convencionales, sino que también abren nuevas oportunidades para la transferencia tecnológica y la aplicación práctica en el campo. Con estos avances, el proyecto ESCUDO sienta las bases para una agricultura y silvicultura más eficientes, resilientes, sostenibles y alineadas con los principios de la economía circular, asegura la investigadora.
Proyectos como ESCUDO reflejan el compromiso de ITENE con el impulso de soluciones biotecnológicas innovadoras que evidencian el potencial de las nuevas tecnologías para promover la sostenibilidad y la economía circular en el sector agrícola a través de herramientas que ayuden a afrontar los desafíos actuales y aseguren un impacto positivo duradero.























